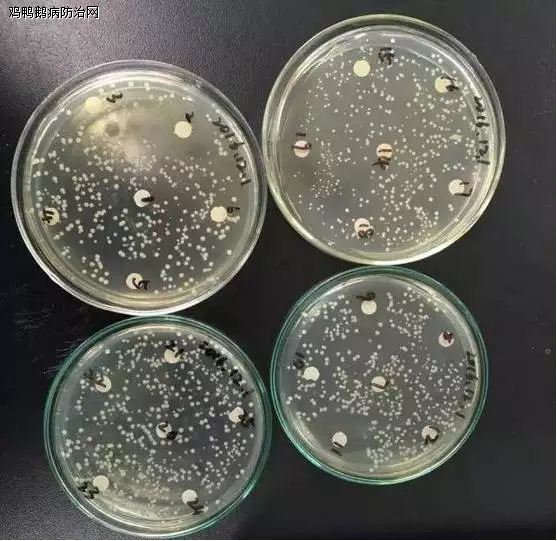

鸡鸭鹅病防治网联合驰骋祥兽医研究所共同分享:
该养殖户为黑龙江省某地区大型合作社,最多时种鹅高达3万只以上,在近几天以来,鹅群出现大量死亡,且发病周期长,给治疗增加了难度。现根据此户病鹅的现场解剖、疾病检测结果、发病原因、总结等编辑成文,分享给大家,希望养殖户读者能引以为戒,加以重视。此总结纯属个人观点,若有不对之处望见谅!。
区域: 黑龙江省某地区
品种: 种鹅
规模: 6000+只
当前数量: 6000只
日龄: 120天以上
死亡数量: 最多70只/天
时间:2016年11月30日
解剖现场
剖检症状:
1、十二指肠充血。
2、肠道黏膜脱落,呈牛舌状。
3、胰腺严重出血点。
4、喉头有粘液。
5、气管出血。
6、腺胃乳头出血。
初步诊断:温和型流感+大肠杆菌。
检测流程及结果
根据检测结果进行给药,投药1天,由于发病周期长,死亡率高,看最后治疗情况吧!会每天进行电话跟踪。
总结
1、种鹅舍消毒不彻底、不及时。
2、种鹅舍全年粪便清理不及时、不彻底。
3、此病发病周期长,发病严重,死亡率高。
4、此养殖户饲喂的主要方式是:湿玉米漏+玉米+精料,建议养殖户,特别是种鹅养殖户不要采用饲喂玉米漏。
5、购买的种鹅在购买前未做相关免疫,增加风险。
玉米漏的危害
1.每位养殖户选择购买玉米漏是因为价格低廉,多少有一定营养,但是不管是干漏还是湿漏都会发生霉变,产生黄曲霉菌,造成鹅体出现大肠杆菌的概率增加。
2.不同的价格,营养成分不等,发生霉变的速度也不同,有些养殖户采用投放脱霉剂,但是,第一,脱霉剂同玉米漏混合在一起后,两者还没有发生反应或反应时间短,就直接投喂,没有起到完全脱霉效果。第二,玉米漏多以堆放为主,发霉部位、发霉程度等有所不同,造成脱霉剂 同玉米漏发生反应的效果有所不同,严重影响脱霉效果。
3.长期投喂玉米漏会发生大肠杆菌疾病,造成群体经常性出现零星死亡,大群常伴有拉稀现象,特别是种鹅,严重影响第二年的产蛋性能,同时长期拉稀现象会造成场区细菌的不断积累,一旦到达极限便会出现场区至少3年不能使用。
4.长期拉稀同时也继发其他疾病的发生。
最后希望各养殖户能够对以上出现发病原因,加以重视,降低不必要的经济损失。谢谢!
①蛋鸡、种鸡:每间隔30天使用“驰骋芪贞颗粒”+ 驰骋EAD乳液+养殖安混合使用;一个疗程(3-4天)
②白羽肉鸡:每间隔10天使用“驰骋芪贞颗粒”+驰骋EAD乳液+养殖安混合使用。一次使用4天。抗菌药物最佳选择“好得快或替嘉康”,可以配合使用达到预防或治疗气囊炎的发生。
③种鸭鹅、种鹅、肉鸭鹅、肉鹅:每月间隔20天使用“驰骋芪贞颗粒 +驰骋EAD乳液+养殖安混合使用;一个疗程(4-5天)
预防禽流感等烈性传染病的消毒模式:
1、改善水质、净化养殖环境:用驰骋一片净,每周三定期消毒一次,即可达到净化养殖环境目的。经过数百家养殖企业使用证明:选用驰骋一片净,消毒效果好!对多种病毒、细菌、真菌有效率达93%-98.5%。
2、杀灭真菌霉菌孢子、清除场地霉菌滋生:用驰骋真霉克,每半月定期饮水消毒一次,即可杀灭畜禽体内霉菌孢子、真菌孢子的生长;杀灭场地霉菌孢子的方法,建议每周至少在畜禽生长、活动的场地内喷雾消毒一次。
3、杀灭蚊蝇:每半月用驰骋蚊蝇一喷净或特制蚊虫一扫光,喷雾一次,即可减少舍内蚊蝇等传播媒介的滋生。
---------------------------------祛除棚舍氨气、空气净化首选--驰骋一片净(减少呼吸道疾病传播);
清理水线,用驰骋一片净,水体净化消毒,要用驰骋一片净—— 清洗水线、饮水消毒、调理肠道、改善水质、清除毒素!五效合一!可带鸡鸭鹅使用,使用方便,效果突出!杜绝病从口入,减少畜禽疫病发生!
鸡鸭鹅鸭鹅病防治网为规模化养殖企业(场)提供疫病防控最佳解决方案!!!http://gallops99.blog.163.com/
禽病实战专家咨询:13939028068 (技术总监-魏老师 个人 微信:CC-zbs 欢迎交流)博客:http://blog.sina.com.cn/gallopsbj
养殖安、驰骋钙、新力爽等产品销售顾问:成龙在路上 13838248089 博客: http://lyrswcl.blog.163.com
来源:鸡鸭鹅鸭鹅病防治网 分享 http://www.jyebfz.com 中兽医 http://www.中兽医.com

驰骋种禽疫病防控专家魏老师建议使用药物预防禽流感:
驰骋种禽疫病防控专家魏老师建议使用药物预防禽流感:






发表评论共有0访客发表了评论
暂无评论,快来抢沙发吧!